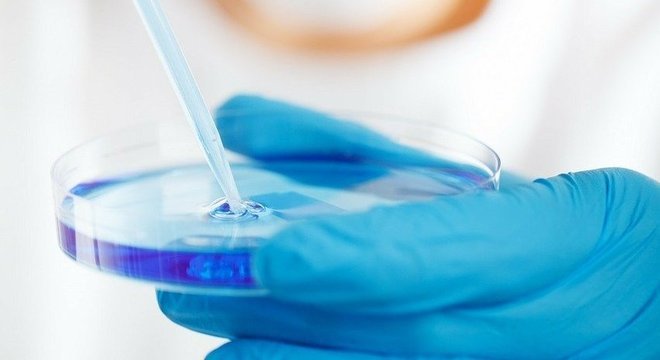

Cientistas britânicos rastrearão a disseminação do novo coronavírus e observarão mutações emergentes usando sequenciamento genético para analisar as cepas que estão causando milhares de infecções de Covid-19 no país, disse o Reino Unido nesta segunda-feira.
Leia também: Sintomas, contágio, prevenção: tire dúvidas sobre o novo coronavírus
Pesquisadores coletarão dados de amostras de pacientes infectados da Inglaterra, País de Gales, Escócia e Irlanda do norte, informou o governo em um comunicado.
Ao menos 281 britânicos morreram de Covid-19, a doença causada pelo novo coronavírus, que se espalhou pelo mundo e se tornou uma pandemia.
"Este vírus é uma das maiores ameaças que nossa nação enfrentou nos últimos tempos, e é crucial para nos ajudar a combatê-la entender como está se disseminando", disse Sharon Peacock, diretora do serviço nacional de infecções da Saúde Pública da Inglaterra (PHE).
Leia também: O que posso fazer para me proteger e evitar transmitir coronavírus?
Trabalhando em equipes em todo o Reino Unido, cientistas mapearão e analisarão os códigos genéticos completos das amostras de Covid-19.
"O sequenciamento genômico nos ajudará a entender a Covid-19 e sua disseminação. Ele também pode ajudar a direcionar tratamentos no futuro e ver o impacto das intervenções", explicou Patrick Vallance, principal conselheiro científico do governo, no comunicado.
Em epidemias, o sequenciamento genômico pode ajudar os cientistas a monitorar pequenas mudanças no vírus em escala nacional ou internacional para compreender como ele está se propagando e se cepas diferentes estão emergindo.
"Neste momento, as questões importantes que podemos ajudar a responder com o sequenciamento são para ajudar a entender o papel das importações internacionais para o Reino Unido", disse Nick Loman, professor de genômica microbiana e bioinformática da Universidade de Birmingham.
O projeto de 23 milhões de dólares, batizado de Consórcio de Genômica do Covid-19 do Reino Unido, será coliderado pelo Instituto Wellcome Sanger, especializado em pesquisa genética, pelo PHE e por outras agências públicas de saúde, além do Serviço Nacional de Saúde e várias instituições acadêmicas.
"Todos os vírus acumulam mutações ao longo do tempo, algumas mais rápidas que outras", disse Paul Klenerman, professor da Universidade de Oxford que se envolverá no trabalho. "Para a Covid-19, isto só está começando, mas esta variação emergente pode ser rastreada detalhadamente."






0 comentários:
Enviar um comentário